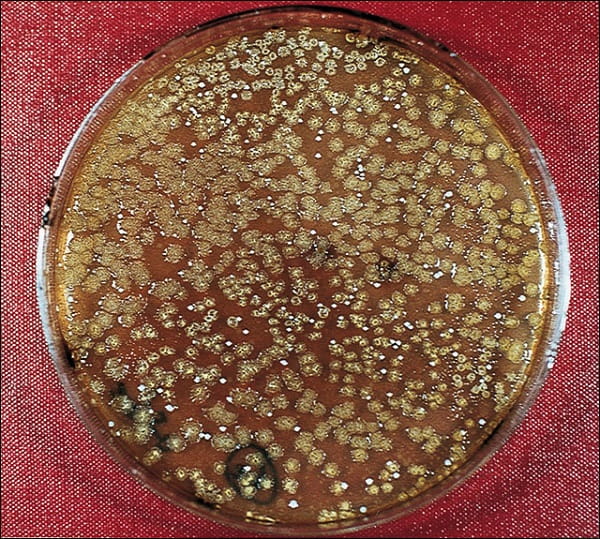

Azoo 11in1 Super-Bio Bacteria Biostarter 120ml
 Opis
Opis
Azoo 11in1 Super-Bio Bacteria Biostarter 120ml
Azoo 11in1 Super-Bio Bacteria to wysokiej klasy biostarter bakteryjny przeznaczony do akwariów słodkowodnych, roślinnych oraz morskich. Preparat zawiera aktywne kultury mikroorganizmów, które natychmiast wspierają filtrację biologiczną i stabilizują cykl azotowy w zbiorniku.
Zastosowane szczepy bakterii skutecznie przyspieszają rozkład amoniaku (NH4), azotynów (NO2) oraz siarkowodoru (H2S), ograniczając nagromadzenie toksycznych substancji i poprawiając klarowność wody. Regularne stosowanie zmniejsza stres ryb i wspiera zdrową równowagę biologiczną akwarium.
Zalety produktu:
- ✅ Zawiera wieloszczepowe bakterie filtracyjne
- ✅ Natychmiast aktywuje filtr biologiczny
- ✅ Redukuje NH4, NO2 oraz H2S
- ✅ Zapobiega syndromowi nowego akwarium
- ✅ Poprawia przejrzystość i jakość wody
- ✅ Bezpieczny dla ryb, krewetek i roślin
Skład:
Produkt mikrobiologiczny zawierający wyselekcjonowane szczepy bakterii takich jak Bacillus sp., Lactobacillus sp., Streptococcus sp., enzymy oraz naturalne substancje wspomagające procesy biologiczne.
Zastosowanie / Sposób użycia:
Preparat przeznaczony do nowo zakładanych oraz dojrzałych akwariów. Zalecany po czyszczeniu filtra, podmianach wody, leczeniu ryb oraz w sytuacjach zwiększonego obciążenia biologicznego.
Dawkowanie:
Stosować regularnie w niewielkich dawkach, najlepiej co tydzień, aby utrzymać stabilną i aktywną filtrację biologiczną. Dawka może być zwiększona przy starcie akwarium lub po ingerencjach w filtr.
FAQ - Najczęściej zadawane pytania:
Czy preparat nadaje się do nowego akwarium?
Tak. Produkt skutecznie przyspiesza start biologiczny zbiornika.
Czy można stosować w akwarium morskim?
Tak. Preparat jest bezpieczny dla systemów morskich i rafowych.
Czy preparat zmienia parametry pH?
Nie. Działa biologicznie bez wpływu na pH i twardość wody.
Czy można łączyć z innymi bakteriami?
Tak. Może być stosowany równolegle z innymi preparatami bakteryjnymi.
Czy produkt jest bezpieczny dla krewetek?
Tak. Przy prawidłowym stosowaniu jest w pełni bezpieczny.
Azoo 11in1, Super-Bio Bacteria, biostarter, bakterie akwariowe, filtracja biologiczna, NH4, NO2, H2S, akwarium słodkowodne, akwarium morskieTagi produktu
EAN: 4714954400088

Wyświetlane są wszystkie opinie (pozytywne i negatywne). Nie weryfikujemy, czy pochodzą one od klientów, którzy kupili dany produkt.